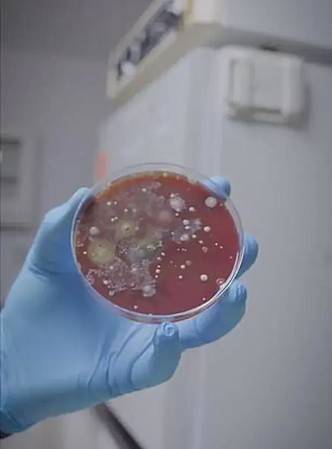

Москва, 07.05.2023, 20:26:21, редакция FTimes.ru, автор Елена Галицкая.
Сушилки для рук в кафе, ресторанах, торговых центрах — это очень удобно и современно. Но безопасно ли их использование? Ответ на этот вопрос искал ФТаймс.
Удобно и быстро

Сушилки в кафе и ресторанах обычно предназначены для быстрого и удобного высыхания кожи рук после мытья. Они могут быть особенно полезны, когда руки мокрые и нет доступа к бумажным полотенцам или другим средствам для вытирания. В кафе и ресторанах, где посетители постоянно приходят и уходят, сушилки для рук могут помочь сократить время, которое посетители проводят в туалетной комнате, что улучшает общий сервис и повышает удобство для клиентов. Однако использование общих сушилок может быть небезопасным для здоровья в период инфекционных заболеваний.
Чем опасны сушилки для рук в ресторанах и торговых центрах

Сушилки в кафе и ресторанах могут быть опасными для здоровья, поскольку они могут распространять бактерии и вирусы от предыдущих пользователей. Это особенно важно в период инфекционных эпидемий, в том числе пандемии COVID-19. Вместо использования общей сушилки, рекомендуется вытирать руки бумажными полотенцами.
Эпидемиолог Эрик Фейгл-Динг из комитета Всемирной организации здравоохранения провел необычный эксперимент и обнародовал его результаты, чтобы поведать людям, почему пользоваться сушилками для рук в общественных местах опасно.
Для того чтобы доказать свою теорию, Эрик взял чашку Петри — это прозрачная лабораторная емкость с крышкой, которую биологи обычно используют для хранения питательной среды, культивируя в ней клетки бактерий, грибов и мелких мхов. Он подставил ее под сушилку для рук на 3 минуты в одном из торговых центров.
Спустя буквально 48 часов (инкубационный период для размножения бактерий) в ней стали появляться грибы и плесень. Выглядело это, мягко говоря, нелицеприятно.

По словам эпидемиолога, сушилки для рук, находящиеся в уборных, целыми днями впитывают воздух из туалета с фекальными испарениями, грибами и болезнетворными бактериями. Потом его они распыляют на ладони людей. Таким образом, вымытые после похода в туалет руки автоматически снова становятся грязными.








































